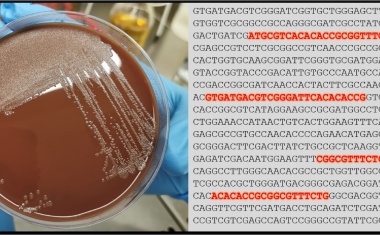
Photo

Die Rechnung ohne den Wirt gemacht: Übertragung der Tuberkulose hängt nicht nur vom Erreger ab
Weltweit existieren verschiedene Gruppen von TB-Bakterien mit unterschiedlicher regionaler Ausbreitung: Manche sind Generalisten und auf vielen Kontinenten zu finden, andere sind in ihrer Ausbreitung sehr begrenzt.